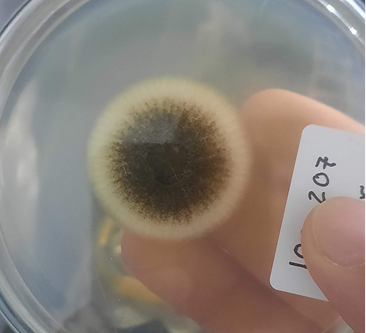
20250221_095814_edited_edited.png

PROJETOS

Na Synth Biotec, desenvolvemos projetos voltados para a produção de bioinsumos, enzimas e outros produtos biotecnológicos inovadores. Também atuamos na imobilização desses materiais em diferentes suportes, com o objetivo de aumentar sua estabilidade, eficiência e rendimento em aplicações industriais. Nesta seção, apresentamos projetos que refletem nossa missão de transformar ciência em soluções práticas, eficientes e sustentáveis ​​para um futuro impulsionado pela biotecnologia.

Estudo Metabólico de Espinosinas em Saccharopolyspora spinosa para Engenharia de Biossíntese em Escherichia coli
Desenvolvimento e otimização de via heteróloga para biossíntese de espinosinas em Escherichia coli, visando a produção eficiente e escalável desses compostos para aplicação da agricultura.

Produção de enzimas para a indústria cervejeira
Produção de enzimas específicas para aplicação na indústria cervejeira, com foco na otimização do processo de produção, melhoria da clarificação, aumento do rendimento de açúcares fermentáveis e padronização da qualidade final da cerveja. O projeto alia biotecnologia e inovação para atender às demandas técnicas do setor.

Produção de enzimas livres e nanosuportadas de interesse em indústrias de alimentos e bebidas
Obtenção de enzimas em formas livres e imobilizadas em nanosuportes, com foco em aplicações que agregam valor e eficiência a processos nas indústrias de alimentos e bebidas.

Produção de enzimas via aproveitamento de resíduos da Amazônia Legal
Desenvolvimento de bioprocessos para a produção de enzimas utilizando resíduos agroindustriais oriundos da Amazônia Legal como substratos. A iniciativa alia inovação biotecnológica à valorização de biomassa regional, promovendo o reaproveitamento de materiais subutilizados .
Produção de celulases a partir de resíduos lignocelulósicos da cidade de Niterói para as indústrias de Bioetanol
Produção de celulases por meio do aproveitamento de resíduos lignocelulósicos gerados na cidade de Niterói, visando atender à demanda das indústrias de bioetanol por enzimas eficientes e sustentáveis.

Produção de amilases industriais através de resíduos agrícolas
O projeto visa produzir amilases com aplicação industrial a partir do aproveitamento de resíduos agrícolas como substrato. A proposta integra sustentabilidade e biotecnologia, promovendo o reaproveitamento de biomassa e a geração de enzimas de interesse para os setores alimentício, têxtil e de biocombustíveis.

.png)